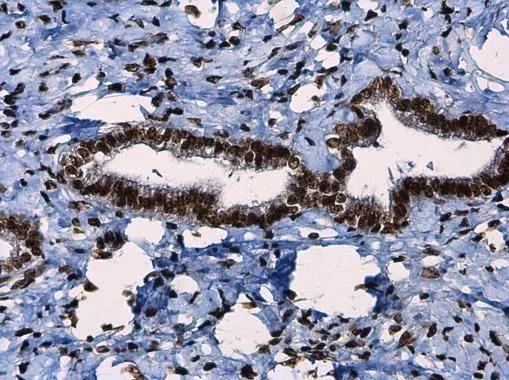
ATR (phospho Thr1989) antibody detects ATR (phospho Thr1989) protein at nucleus in human breast carcinoma by immunohistochemical analysis. Sample: Paraffin-embedded human breast carcinoma. ATR (phospho Thr1989) antibody (GTX128145) diluted at 1:250. 
 Antigen Retrieval: Citrate buffer, pH 6.0, 15 min
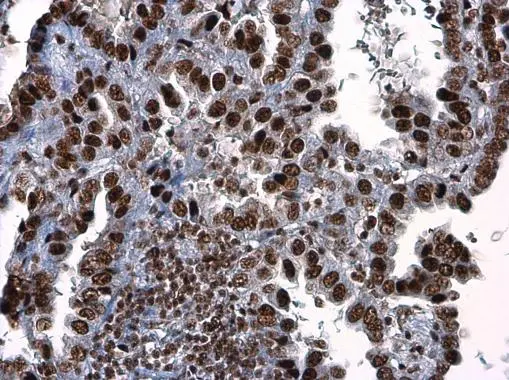
ATR (phospho Thr1989) antibody detects ATR (phospho Thr1989) protein at nucleus in human colon cancer by immunohistochemical analysis. Sample: Paraffin-embedded human colon cancer. ATR (phospho Thr1989) antibody (GTX128145) diluted at 1:250. 
 Antigen Retrieval: Citrate buffer, pH 6.0, 15 min
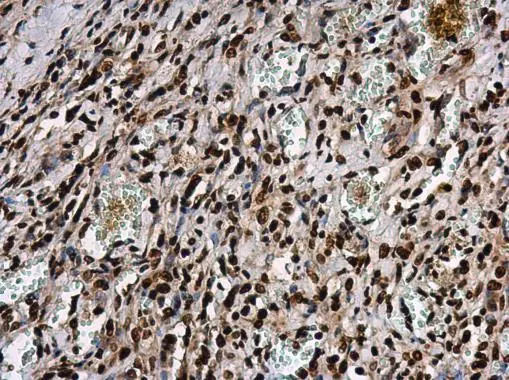
ATR (phospho Thr1989) antibody detects ATR protein at nucleus in human lung cancer by immunohistochemical analysis. Sample: Paraffin-embedded human lung cancer. ATR (phospho Thr1989) antibody (GTX128145) diluted at 1:250. 
 Antigen Retrieval: Citrate buffer, pH 6.0, 15 min

Untreated (–) and treated (+) HeLa whole cell extracts (30 μg) were separated by 5% SDS-PAGE, and the membrane was blotted with ATR (phospho Thr1989) antibody (GTX128145) diluted at 1:1000. The HRP-conjugated anti-rabbit IgG antibody (GTX213110-01) was used to detect the primary antibody.
ATR (phospho Thr1989) antibody
GTX128145
ApplicationsImmunoFluorescence, ImmunoPrecipitation, Western Blot, ImmunoCytoChemistry, ImmunoHistoChemistry, ImmunoHistoChemistry Paraffin
Product group Antibodies
ReactivityHuman, Mouse
TargetATR
Overview
- SupplierGeneTex
- Product NameATR (phospho Thr1989) antibody
- Delivery Days Customer9
- Application Supplier NoteWB: 1:500-1:3000. ICC/IF: 1:100-1:1000. IHC-P: 1:100-1:1000. IP: 1:100-1:500. *Optimal dilutions/concentrations should be determined by the researcher.Not tested in other applications.
- ApplicationsImmunoFluorescence, ImmunoPrecipitation, Western Blot, ImmunoCytoChemistry, ImmunoHistoChemistry, ImmunoHistoChemistry Paraffin
- CertificationResearch Use Only
- ClonalityPolyclonal
- Concentration0.07 mg/ml
- ConjugateUnconjugated
- Gene ID545
- Target nameATR
- Target descriptionATR checkpoint kinase
- Target synonymsFCTCS, FRP1, MEC1, SCKL, SCKL1, serine/threonine-protein kinase ATR, ATR serine/threonine kinase, FRAP-related protein-1, MEC1, mitosis entry checkpoint 1, homolog, ataxia telangiectasia and Rad3-related protein
- HostRabbit
- IsotypeIgG
- Protein IDQ13535
- Protein NameSerine/threonine-protein kinase ATR
- Scientific DescriptionThe protein encoded by this gene belongs the PI3/PI4-kinase family, and is most closely related to ATM, a protein kinase encoded by the gene mutated in ataxia telangiectasia. This protein and ATM share similarity with Schizosaccharomyces pombe rad3, a cell cycle checkpoint gene required for cell cycle arrest and DNA damage repair in response to DNA damage. This kinase has been shown to phosphorylate checkpoint kinase CHK1, checkpoint proteins RAD17, and RAD9, as well as tumor suppressor protein BRCA1. Mutations of this gene are associated with Seckel syndrome. An alternatively spliced transcript variant of this gene has been reported, however, its full length nature is not known. Transcript variants utilizing alternative polyA sites exist. [provided by RefSeq]
- ReactivityHuman, Mouse
- Storage Instruction-20°C or -80°C,2°C to 8°C
- UNSPSC41116161